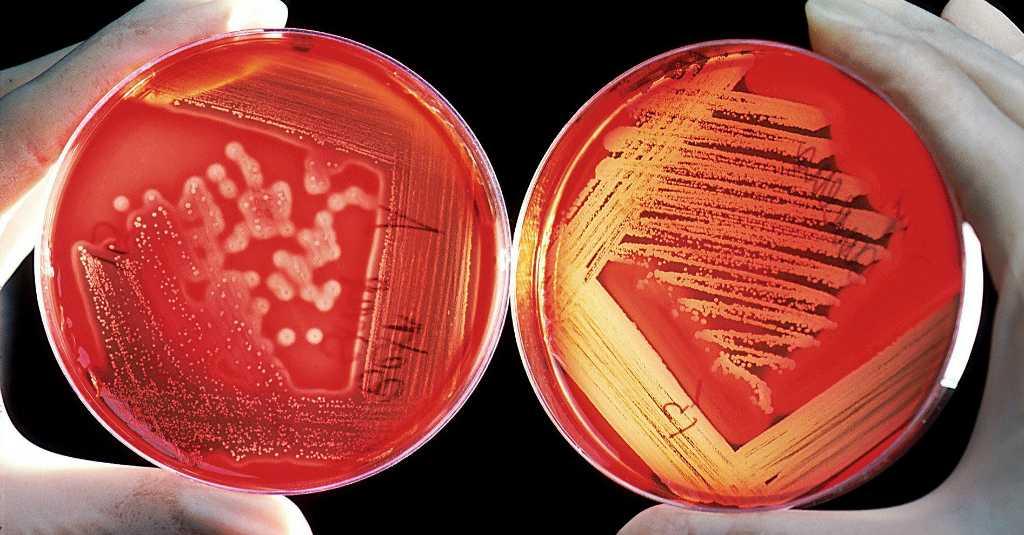

Pantau.com - Keseimbangan mikrobiota dalam tubuh anak salah satunya ditentukan melalui metode persalinan.
Anak yang lahir melalui prosedur persalinan caesar, berisiko mengalami ketidakseimbangan mikrobiota di ususnya dan berdampak pada sistem imunnya.
Kabar baiknya, profil mikrobiota ini bisa diseimbangkan pada awal kehidupan hingga usia anak tiga tahun, menurut dokter anak konsultan gastro hepatologi, Prof. Moh Juffrie.
Baca juga: Amankah Menerapkan Pola Makan Vegan Kepada Anak?
Hal yang bisa dilakukan, pemberian ASI eksklusif, karena di dalamnya terkandung lebih dari 200 spesies mikroorganisme yang dikenal sebagai probiotik dan human milk oligosaccharides atau yang dikenal sebagai prebiotik.
"Kombinasi probiotik dan prebiotik yang bekerja sinergis dan memberikan efek, dikenal juga dengan Sinbiotik, dapat membantu mempercepat kolonisasi bakteri baik dan meningkatkan jumlah bakteri baik seperti Bifidobacterium pada Si Kecil yang lahir secara caesar," kata dia.
Selain ASI, pemberian makanan sehari-hari (untuk anak yang sudah bisa mendapatkan MPASI) juga bisa membantu.
Pilihannya buah-buahan seperti apel, pisang dan bengkuang, makanan yang terdapat bawang merah, bawang bombay di dalamnya atau minuman probiotik yang sudah tersedia di pasaran.
"Makanan mengandung probiotik, makanan lokal yang sedikit asam misalnya gatot atau gaplek (singkong) yang difermentasi mengandung Lactobacillus," tutur Juffrie.
Baca juga: Jika Anak Terlanjur Obesitas, Segera Lakukan Metode Ini!
Mikrobiota hidup di berbagai organ tubuh, salah satunya saluran cerna. Mikrobiota di saluran cerna mengandung jutaan mikroba yang dianggap penting untuk mengembangkan sistem imunitas tubuh.
Dokter konsultan obstetri & ginekologi dan konsultan fetomaternal di Rumah Sakit Cipto Mangunkusumo (RSCM), Ali Sungkar mengatakan, paparan pertama dengan komunitas mikrobiota maternal (vagina, feses, ASI, mulut dan kulit) akan menentukan kematangan usus, perkembangan metabolik dan imunologi serta konsekuensi status kesehatan jangka pendek dan jangka panjang.
rn- Penulis :
- Gilang









